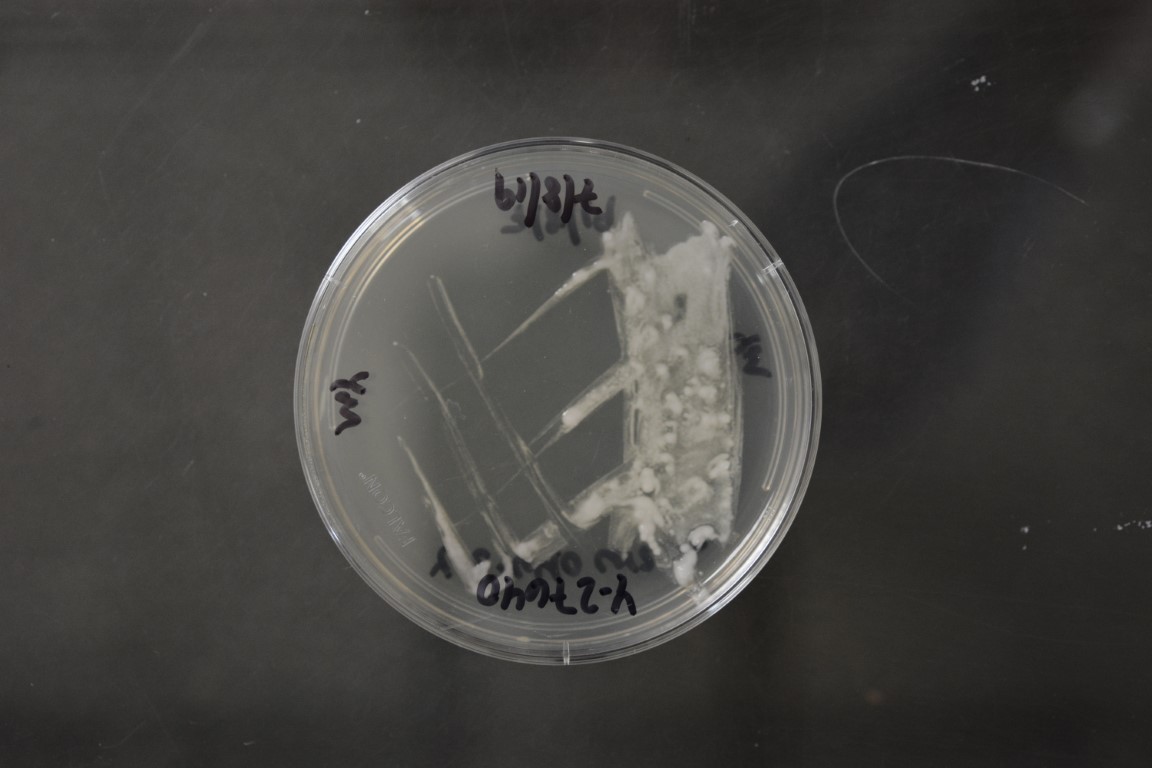

Candida bombiphila
NRRL Y-27640(Type Strain)
Accession numbers in other collections:CBS 9712
Source:Andre Lachance,Univ.of Western Ontario,London,Ontario,Canada
Isolated from(substrate):IN,proboscis of a bumble bee(Bombus terrestris)queen,early spring
Substrate location:New Botanical Garden of Philipps University,Marburg,Germany
Genetic info:GenBank:D1/D2(AJ620185).
Growth media:Yeast Extract-Malt Extract-Peptone-Glucose(YM for yeasts)(number 6)
Optimum growth temperature:25C
Strain images:
NRRL_Y-27640_6.JPG

Comments:Wickerhamiella clade